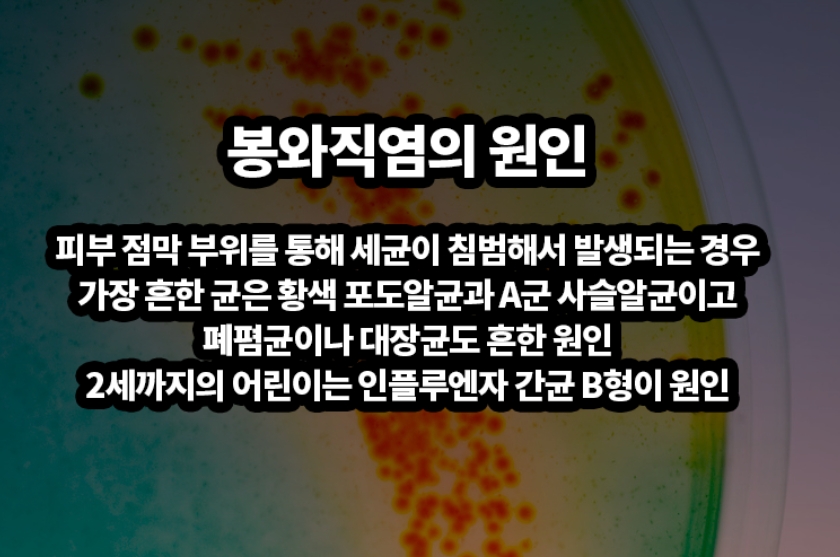

2023. 11. 11. 16:46ㆍ카테고리 없음
- 목차
눈밑 부어오름 요인 9가지
눈밑이나 전신이 부어오르는 부종은 보통 아침에 경험하는 경우가 많은데 대부분 짜게 먹고 물을 많이 먹었을 때 자주 붓지만 눈밑 부어오름은 안과 질환을 비롯한 다양한 신체 질환의 전조 증상으로 나타나기도 합니다. 특히 눈 주위의 피부는 매우 얇고 눈에 잘 띄기 때문에 붓기나 변색이 쉽게 눈에 띄게 됩니다.
눈밑의 붓기는 알레르기 또는 누관 막힘과 같은 경미한 질환으로 발생하기도 하지만 장기 부전과 같은 심각한 질환 등으로 발생하는 등 다양한 원인으로 발생할 수 있습니다. 또한 눈 주위의 붓기는 주변 피부 조직에 과도한 체액 축적으로 인해 발생하기도 합니다.
![]() |
![]() |
눈 주변의 피부는 상당히 예민하기 때문에 수면 중에 닫히고 깜박이지 않는 눈꺼풀은, 붓기에 예민하고 취약한 사람은 쉽게 부을 수 있습니다. 때문에 아침에는 비정상적으로 부은 눈꺼풀로 깨어날 수 있지만, 기상과 함께 눈을 깜빡이기 시작하면 붓기가 점차 사라지게 됩니다.
눈 아래의 부종은 종종 심한 붓기를 유발하여 눈이 부분적으로 닫힐 수 있습니다. 근본 원인에 따라 한쪽 또는 양쪽 눈에 영향을 미칠 수 있으며, 일부 조건의 경우 눈 변색, 가려움, 멍, 찢어짐 또는 분비물과 같은 다른 증상과 함께 부기가 발생할 수 있습니다. 또 다른 눈밑 부어오름 증상을 유발 할 수 있는 요인을 알아보겠습니다.
1. 스마트폰 사용
스마트폰이나 컴퓨터 과다 사용은 눈밑 부어오름뿐만 아니라 안구 건조증과 눈의 피로를 유발 할 수 있습니다. 특히 아이들부터 노인에 이르기 까지 대부분의 현대인들은 많은 시간동안 전자기기를 사용하게 되는데 과도한 사용은 눈밑 부어오름뿐만 아니라 건강에도 큰 문제가 될 수 있습니다.
![]() |
![]() |
2. 눈 부상
눈밑이 붓는 것은 부상을 나타낼 수 있습니다. 상처 나 타박상은 부기나 변색, 통증을 유발할 수 있습니다. 또한 눈 근처를 모기와 같은 해충에 물리면 붓기를 유발할 수 있습니다. 이런 작은 눈 주변 부상은 부위를 깨끗하고 건조하게 유지하면 쉽게 치유 될 수 있습니다.
3. 안구 감염
눈에 오염이 되거나 염증이 생겨 눈물샘이 막혀도 눈에 부종이 발생할 수 있습니다. 또한 눈물샘에 부상 또는 염증 등으로 인해 누관이 막힐 수 있습니다. 누관 막힘이나 부상의 경우 저절로 해결 될 수 있지만 감염에는 항생제 가 필요할 수 있습니다 .
4. 다래끼
다래끼는 속눈썹 부위에서 발생하는 감염으로, 다래끼가 있을 때는, 눈에 이물질이 있는 것처럼, 느낄 수 있으며 부기가 나타날 수 있습니다. 다래끼가 나면, 빛에 민감해 지거나 염증이 발생 할 수 있습니다. 다래끼는 시간이 지나면 그냥 낫기도 하지만 호전되지 않으면 항생제를 처방하거나 배액 해야 할 수 있습니다.
![]() |
![]() |
5. 눈 알레르기
눈 알레르기는 눈이 부어오르게 할 수 있습니다. 특정 음식이나 화학 물질에 대한 반응과 같은 다른 유형의 알레르기도 눈밑이 부어오르게 할 수 있습니다. 알레르기 반응이 일어날 동안은 신체의 특정 세포는 히스타민이라는 화학 물질을 방출하게 되고, 이로 인해 혈관에서 체액이 누출되어 눈 주위를 포함한 주변 조직에 부종이 발생할 수 있습니다.
6. 봉와직염
안구 주위 봉와직염은, 눈 근처의 상처가 감염 될 때 발생합니다. 심한 눈밑 부어오름, 통증 및 염증을 유발 할 수 있습니다. 한 기사 에 따르면 봉와직염은, 소아에서 가장 흔하며 종종 외상이나 부비동염으로 인해 발생하기도 합니다. 치료는, 배액과 항생제 등이 포함될 수 있습니다
![]() |
![]() |
7. 알레르기
꽃가루 및 애완동물 털과 같은 알레르겐은 눈을 자극하여 알레르기 반응을 일으킬 수 있습니다. 이런 알레르기 체질인 사람은 코 막힘, 재채기 또는 가려운 인후와 같은 다른 알레르기 증상을 가질 수도 있습니다. 심한 알레르기 반응은 아나필락시스를 유발할 수 있으며 이는 두드러기 ,기도 부종 및 호흡 곤란 을 유발하는 의학적 응급 상황입니다 .
8. 결막염
눈밑 부어오름 원인이 될 수 있는 결막염은, 세균성 또는 바이러스성 안구 감염으로 인해 발생하며, 가렵거나 상처, 충혈, 염증 등이 발생하며, 세균성 안구 감염은, 고름을 생성 할 수 있습니다. 또한 결막염은 전염성이 있으므로 이러한 증상이 있는 사람은 눈을 만지지 말고 빨리 치료를 받아야합니다.
![]() |
![]() |
9. 장기 부전
눈밑 부어오름은 장기 부전으로 인해 눈에서 부종을 통해 전조 증상을 보는 것을 경험할 수 있습니다. 특히, 심장이나 신장 또는 간부전 등이 있으며 이들 장기부전은, 체액 균형을 조절하는 신체 능력에 영향을 미치며, 눈밑 부어오름뿐만 아니라, 발과 신체의 다른 부위에도 부종을 유발 할 수 있습니다.